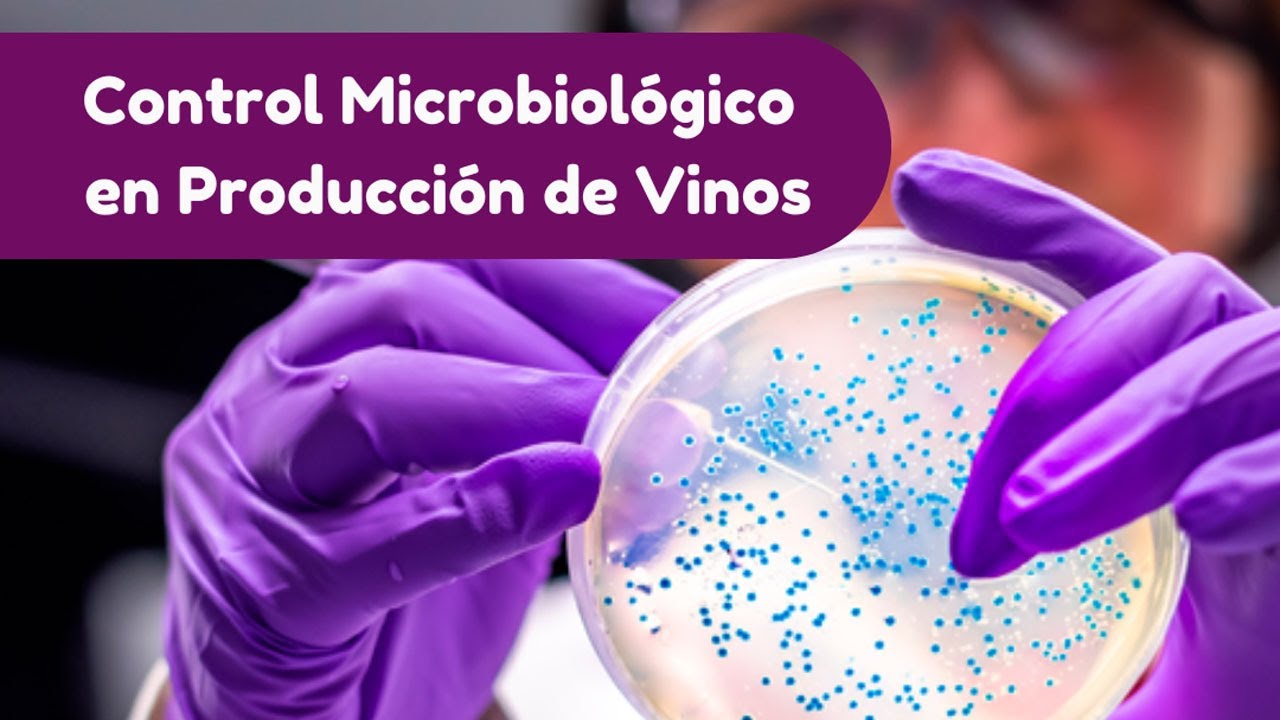
Control Microbiológico en Producción de vinos

Control Microbiológico en Producción de vinos
Автор: Industrias Alimentarias
Загружено: 2022-07-14
Просмотров: 801
Описание:
Control Microbiológico en Producción de vinos
Suscríbete es gratis: / @industriasalimentarias
Повторяем попытку...
Доступные форматы для скачивания:
Скачать видео
-
Информация по загрузке:



















